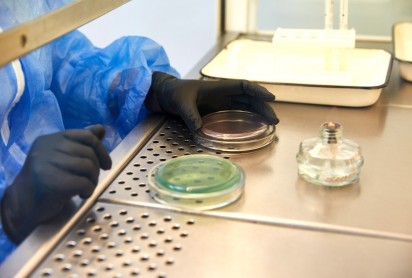
Mikrobiyoloji

Yolun her adımında...
Medikal Cihaz yaşam döngüsünün her noktasında kapsamlı hizmet teklifleri
Lab Partner, danışmanlık, laboratuvar testleri ve mevzuata uygunluk alanlarında küresel bir ortak olarak, ilaç, kimya, kozmetik, tıbbi cihaz ve biyosidal endüstrilerindeki işletmeleri ürün güvenliğini sağlama ve küresel standartları karşılama konusunda destekliyor.
Hizmetlerimiz
Tıbbi Cihazlar İçin
Güvenilir ve Bütünsel Çözümler
Lab Partner olarak hedefimiz, biyouyumluluk test hizmetlerini tüm üreticiler için erişilebilir kılmak ve danışmanlığı sertifikalandırma süreçleriyle tamamlayarak sektörü ileri taşımaktır. Laboratuvar süreçlerinin her aşamasını yeniden kurgulayarak, cihazdan analize ve rapora kadar uzanan bir ekosistem kurma hedefiyle emin adımlarla ilerliyoruz.
LABORATUVARINIZ İÇİN ÇÖZÜM ORTAKLIĞI
Satış ve pazarlamaya ek yatırım yapmadan gelirinizi artırın.
Lab Partner, çevresel testler ve kimyasal analizlerden, ilaç, tıbbi cihazlara ve ambalaj malzemelerine kadar çeşitli sektörlerdeki şirketlere hizmet veren bir laboratuvar test hizmeti sağlayıcısıdır.
Amacımız, müşterilerimizin ihtiyaç duyduğu tüm testleri tek bir platformda rahatlıkla sunmaktır. Dünya çapında 50'yi aşkın laboratuvar kuruluşlarıyla çalışıyoruz ve müşterilerimize daha da iyi hizmet verebilmek için sürekli olarak yeni servis sağlayıcı nitelikte profesyonel iş ortakları arayışımızı sürdürmekteyiz. Bu bağlamda joint venture anlaşmalarımız gün geçtikçe artıyor.